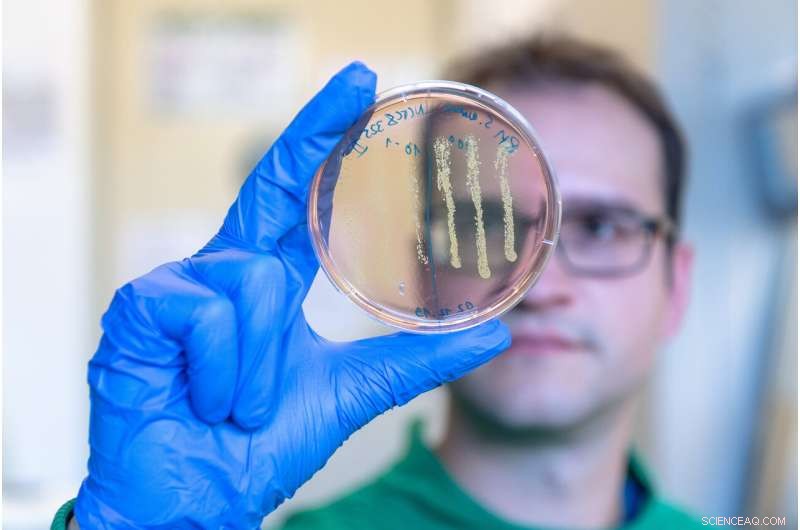
Repurposed Cancer Drug Shows Promise Against Multi-Drug Resistant Bacteria

Scanning electron micrograph of intact MRSA (blue), PK150-induced vesicle formation (green), and MRSA destroyed by PK150 (red). Credit: Manfred Rohde / HZI
Antibiotic-resistant bacteria are increasingly the source of deadly infections. A team of scientists from the Technical University of Munich (TUM) and the Helmholtz Center for Infection Research (HZI) in Braunschweig have now modified an approved cancer drug to develop an active agent against multidrug-resistant pathogens.
The methicillin-resistant Staphylococcus aureus (MRSA) is the source of severe and persistent infections. Some strains are even resistant to multiple antibiotics. There is consequently an urgent need for new drugs effective against MRSA infections.
"The industrial development of new antibiotics is stalling and not keeping pace with the spread of antibiotic resistance. We urgently need innovative approaches to meet the need for new infection therapies that do not lead directly to renewed resistance," says Prof. Eva Medina, director of the HZI Infection Immunology Research Group.
New antibiotic development strategies
One promising strategy is to test the potential effect of approved drugs on bacteria. "Our focus was on a class of human proteins called kinases, which have many inhibitors to begin with," explains study leader Stephan Sieber, professor of organic chemistry at TUM.
In this vein, the researchers chemically modified the active ingredient sorafenib, a cancer drug that is effective against MRSA, to achieve a stronger antibiotic effect. This led to the development of PK150, a molecule 10 times more effective against MRSA than the original substance.
Scientists led by Prof. Stephan Sieber at the Technical University of Munich and Prof. Eva Medina at the Helmholtz Center for Infection Research have modified an approved cancer drug to develop an active agent against multidrug-resistant pathogens. The picture shows author Robert Macsics examining an agar plate on which colonies of Staphylococcus aureus have grown. Credit: Andreas Heddergott / TUM
Multiple attacks prevent the development of resistance
The potent new agent targets various unconventional structures within the bacteria. Two targets were investigated in greater detail: For one, PK150 inhibits an essential protein involved in bacterial energy metabolism. For another, it acts on the cell wall.
In contrast to previously known antibiotics such as penicillin and methicillin, which interfere with cell wall formation, PK150 acts indirectly. It knocks the protein production in bacteria off kilter. As a result, the bacteria release more proteins that control the cell wall thickness to the outside, causing the cells to burst.
In mice, PK150 has proven to be effective against MRSA in a variety of tissues. While staphylococci rapidly develop resistance to other antibiotics, the researchers did not observe the development of any resistance to PK150.

Scientists led by Prof. Stephan Sieber at the Technical University of Munich and Prof. Eva Medina at the Helmholtz Center for Infection Research have modified an approved cancer drug to develop an active agent against multidrug-resistant pathogens. The picture shows author Robert Macsics in the laboratory of the group of Prof. Sieber working at the sterile workbench. Credit: Andreas Heddergott / TUM
Effectiveness against biofilms and persisters
Eva Medina and Dr. Katharina Rox, a pharmacologist from the Department of Chemical Biology at HZI, showed that PK150 has favorable pharmacological properties. It can be administered as a tablet, for example, and remains stable in the body for several hours. "As a result of the chemical changes to the molecule, PK150 no longer binds to human kinases, but acts very specifically against bacterial targets," says Sieber.
And PK 150 has another benefit: "MRSA infections are very often chronic, as the bacteria can become dormant. PK150 even kills these, as well as germs protected in biofilms," says Prof. Dietmar Pieper, head of the HZI research group "Microbial Interactions and Processes."
In the context of the aBACTER project, Prof. Sieber's team is now further optimizing PK150 to enter the clinical development phase.
The study is published in Nature Chemistry.